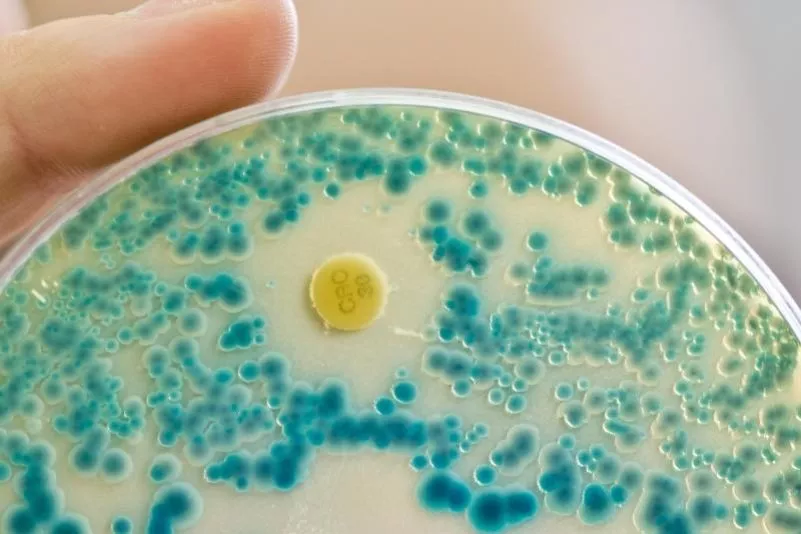
top-article-image

Antibiotikaversorgung in Deutschland hängt "am Tropf Chinas” - Teilweise weltweit nur zwei oder drei Produzenten
Eine aktuelle Studie zeigt eine sehr hohe Abhängigkeit der Antibiotikaversorgung vor allem von Herstellern in China, die bereits wesentliche Teile der gesamten Weltmarktproduktion auf sich vereinigten. Beim Ausfall eines Unternehmens seien Versorgungsengpässe die logische Folge, wie sich zuletzt am Beispiel des Antibiotikums Piperacillin/Tazibactam gezeigt habe.
Indikatorkulturplatte zum Nachweis von resistenten Bakterien: Die Zahl der Krankheitsfälle mit Erregern, die gegen alle gängigen Antibiotika resistent sind, ist 2015 erneut gestiegen.
Foto: Daniel Karmann/Archiv/dpa
Der Pharmaverband Pro Generika hat vor Lieferengpässen bei wichtigen Antibiotika durch die Konzentration der Produktion außerhalb der Europäischen Union gewarnt. Die Antibiotikaversorgung in Deutschland hänge “am Tropf Chinas”, erklärte Verbandsvizechef Markus Leyck-Dieken am Dienstag in Berlin. Angesichts weltweit zunehmender Spannungen sollte sicher gestellt werden, “dass der Erste-Hilfe-Koffer im Ernstfall in Europa steht”.
Eine von Pro Generika in Auftrag gegebenen Studie der Unternehmensberatung Roland Berger zeigt demnach eine sehr hohe Abhängigkeit der Antibiotikaversorgung vor allem von Herstellern in China, die bereits wesentliche Teile der gesamten Weltmarktproduktion auf sich vereinigten. Teilweise gebe es nur zwei oder drei relevante Produzenten.
Beim Ausfall eines Unternehmens seien Versorgungsengpässe die logische Folge, wie sich zuletzt am Beispiel des Antibiotikums Piperacillin/Tazibactam gezeigt habe.
Marktkonzentration wegen hohem Preisdruck
Weltweit existieren den Angaben zufolge nur noch zwei relevante Produktionsstätten für die Herstellung von Wirkstoffen für dieses Breitbandantibiotikum, das bei schweren Infektionen vor allem im stationären Bereich eingesetzt wird. Wegen einer Explosion in einem chinesischen Werk Ende 2016 kam es zu Lieferengpässen.
Für die Marktkonzentration bei der Arzneimittelherstellung macht Pro Generika vor allem den hohen Preisdruck durch die Produktionskosten und die Niedrigpreise für Antibiotika in Deutschland verantwortlich. Die aktuellen Engpässe sollten “ein Weckruf” sein, erklärte Dieken. Nötig sei eine Neuausrichtung der Versorgungssicherheit.
In den vergangenen Jahren war es wiederholt zu Lieferengpässen bei einigen Arzneimitteln gekommen. Betroffen waren neben Antibiotika unter anderem auch Krebsmittel, Schilddrüsenhormone und Impfstoffe. Als Reaktion darauf wurde auf der Website des Bundesinstituts für Arzneimittel und Medizinprodukte eine Datenbank eingerichtet, über die Unternehmen freiwillig Lieferengpässe melden können. (afp)
Kommentare
Noch keine Kommentare – schreiben Sie den ersten Kommentar zu diesem Artikel.
0
Kommentare
Noch keine Kommentare – schreiben Sie den ersten Kommentar zu diesem Artikel.





